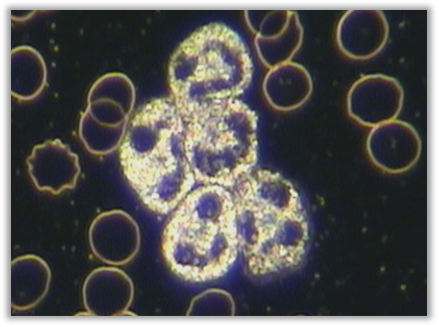

Tag: Live blood analysis
WBCs with Translucent Membrane
A Key Marker of Viral Stress & High Immune Demand Appearance A WBC with a translucent membrane shows a clear, glowing halo surrounding the outer border of the cell. The cytoplasmic edge becomes thin, bright,…
Plasma Cells (Activated Lymphocytes)
Indicators of Active Antibody Production & Chronic Immune Activation Appearance Plasma cells are activated, differentiated lymphocytes that appear when the immune system is actively producing antibodies. In live blood, plasma cells typically show: They are…
Monocytes – Increased / Decreased
Sentinel Cells Reflecting Chronic Inflammation & Tissue Repair Appearance Monocytes are the largest white blood cells. They exhibit: Monocytes are typically easy to distinguish from: Increased Monocytes (Monocytosis) Monocytes increase in conditions involving chronic inflammation,…
Neutrophils: Cohesion
Appearance Neutrophil cohesion occurs when two or more neutrophils stick together, showing: The granulation and nuclear segmentation remain normal, but the cells behave as though magnetised. Meaning & Implications Cohesion indicates activation of inflammatory mediators,…
Neutrophil: Macrocytes
Appearance Macrocytic neutrophils are significantly larger than normal neutrophils, often: Meaning & Implications Macrocytic neutrophils indicate compromised immune development, commonly caused by: A) Nutrient Deficiencies Most commonly: B) Viral or Parasitic Stress Macrocytes often appear…
Neutrophils: Metamyelocytes
Appearance Metamyelocytes are immature neutrophils, more developed than myelocytes but not yet mature. They show: They resemble a transitional stage between myelocytes and band neutrophils. Meaning & Implications Metamyelocytes indicate that the body is responding…
Neutrophils: Myelocytes
Appearance Myelocytes are immature neutrophils released prematurely from the bone marrow. They show: They indicate emergency immune production. Meaning & Implications Myelocytes signify the body is under significant immune stress, usually: A) Acute Infection Especially…
Neutrophils: Disrupted
Appearance Disrupted neutrophils appear damaged, ruptured, or fragmented, showing: Severe cases show the cell essentially burst, with internal material dispersed outward. Meaning & Implications Disrupted neutrophils indicate severe immune distress and are considered one of…
Neutrophils: Band Cells
Appearance Band neutrophils are immature neutrophils characterised by: These represent the stage immediately before full neutrophil segmentation. Meaning & Implications Band cells reflect increased neutrophil production during acute immune stress. A) Acute Bacterial Infection Band…

Disclaimer
Disclaimer